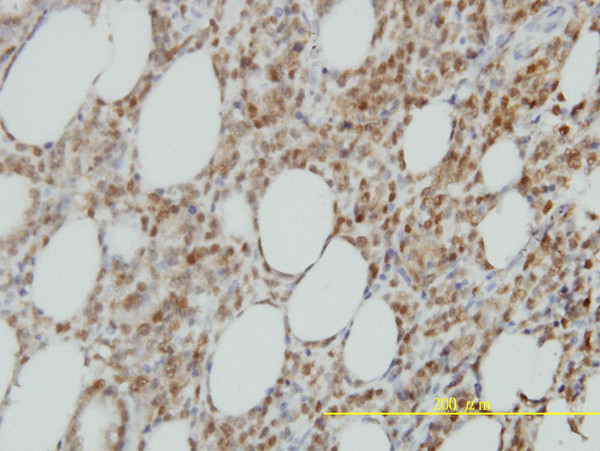
ISGF3G Antibody in Immunohistochemistry (Paraffin) (IHC (P))

Search
Abnova
ISGF3G Monoclonal Antibody (1D11)
{{$productOrderCtrl.translations['antibody.pdp.commerceCard.promotion.promotions']}}
{{$productOrderCtrl.translations['antibody.pdp.commerceCard.promotion.viewpromo']}}
{{$productOrderCtrl.translations['antibody.pdp.commerceCard.promotion.promocode']}}: {{promo.promoCode}} {{promo.promoTitle}} {{promo.promoDescription}}. {{$productOrderCtrl.translations['antibody.pdp.commerceCard.promotion.learnmore']}}
产品信息
H00010379-M02
种属反应
宿主/亚型
分类
类型
克隆号
抗原
偶联物
形式
浓度
规格
纯化类型
保存液
内含物
保存条件
运输条件
产品详细信息
Sequence of this protein is as follows: MASGRARCTR KLRNWVVEQV ESGQFPGVCW DDTAKTMFRI PWKHAGKQDF REDQDAAFFK AWAIFKGKYK EGDTGGPAVW KTRLRCALNK SSEFKEVPER GRMDVAEPYK VYQLLPPGIV SGQPGTQKVP SKRQHSSVSS ERKEEEDAMQ NCTLSPSVLQ DSLNNEEEGA SGGAVHSDIG SSSSSSSPEP QEVTDTTEAP FQGDQRSLEF LLPPEPDYSL LLTFIYNGRV VGEAQVQSLD CRLVAEPSGS ESSMEQVLFP KPGPLEPTQR LLSQLERGIL VASNPRGLFV QRLCPIPISW NAPQAPPGPG PHLLPSNECV ELFRTAYFCR DLVRYFQGLG PPPKFQVTLN FWEESHGSSH TPQNLITVKM EQAFARYLLE QTPEQQAAIL SLV
靶标信息
Transcription factor that plays an essential role in anti-viral immunity. It mediates signaling by type I IFNs (IFN-alpha and IFN-beta). Following type I IFN binding to cell surface receptors, Jak kinases (TYK2 and JAK1) are activated, leading to tyrosine phosphorylation of STAT1 and STAT2. IRF9/ISGF3G associates with the phosphorylated STAT1:STAT2 dimer to form a complex termed ISGF3 transcription factor, that enters the nucleus. ISGF3 binds to the IFN stimulated response element (ISRE) to activate the transcription of interferon stimulated genes, which drive the cell in an antiviral state. [UniProt]
仅用于科研。不用于诊断过程。未经明确授权不得转售。
篇参考文献 (0)
生物信息学
蛋白别名: gamma 48kDa; IFN alpha responsive transcription factor subunit; IFN-alpha-responsive transcription factor subunit; Interferon regulatory factor 9; Interferon-stimulated gene factor 3 gamma; interferon-stimulated transcription factor 3; interferon-stimulated transcription factor 3, gamma (48kD); interferon-stimulated transcription factor 3, gamma 48kDa; IRF-9; ISGF-3 gamma; ISGF3 p48 subunit; Transcriptional regulator ISGF3 subunit gamma; unnamed protein product
基因别名: IRF-9; IRF9; ISGF3; ISGF3G; p48
UniProt ID: (Human) Q00978
Entrez Gene ID: (Human) 10379